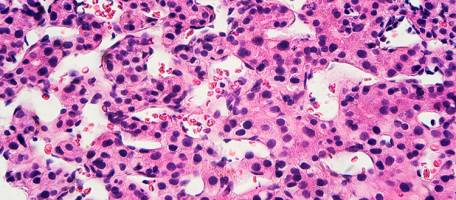
Cancer du foie: attention � l'h�patite D

actualités
Université de Genève
Résultats 381 - 400 de 711.
Sciences de la vie - Santé - 03.08.2020

La découverte d'un mécanisme impliqué dans la synthèse de la membrane du staphylocoque doré pourrait contribuer à la lutte contre cette bactérie difficile à traiter. Les staphylocoques dorés ont la capacité de se développer dans des conditions environnementales très variables (sur la peau, dans le nez, sur des surfaces stériles, etc.
Sciences de la vie - Politique - 29.07.2020

La médiation par un tiers a des effets positifs sur l'issue d'une dispute au sein d'un couple comme en témoigne l'activité accrue de régions clés du cerveau appartenant au circuit de la récompense. Lors d'un conflit de couple, la médiation par un tiers améliore l'issue de la confrontation. Mais ce n'est pas tout.
Astronomie & Espace - Physique - 28.07.2020

Une collaboration internationale entre des télescopes au sol et en orbite éclaire l'un des mystères de l'univers. L'alerte a été lancée par l'observatoire spatial Integral de l'ESA, dont les données scientifiques sont traitées à l'Université de Genève. Un réseau international de télescopes, dont fait partie Integral, l'observatoire spatial à haute énergie de l'ESA (Agence spatiale européenne), a permis de détecter un mélange unique de radiations provenant d'une étoile morte dans notre galaxie.
Santé - 22.07.2020
Le rôle de la médecine de famille dans l’épidémie de COVID-19
Avec une étude couvrant 1500 patients ambulatoires, une équipe de l'Université de Genève met en lumière le rôle crucial que pourraient jouer les médecins généralistes dans le contrôle du COVID-19. La crise du COVID-19 a amené les gouvernements à s'appuyer sur l'expertise de spécialistes dans la définition des politiques d'urgence sanitaire.
Santé - Sciences de la vie - 15.07.2020

Une étude menée menée par l'Université de Genève et les HUG montre que les bébés présentant des pleurs excessifs (coliques du nourrisson) sont dès leur naissance plus sensibles à certaines odeurs. Pourquoi certains nourrissons pleurent-ils beaucoup plus que d'autres - Les pleurs font partie de la vie d'un nourrisson et représentent une forme de communication avec leur entourage.
Santé - Sciences de la vie - 13.07.2020

Des chercheurs de l'Université de Genève montrent comment la protéine Vav3, en créant des «stations d'ancrage à bactéries», facilite l'infection des voies respiratoires des personnes atteintes de mucoviscidose. La mucoviscidose, l'une des maladies génétiques les plus fréquentes en Suisse, provoque des troubles respiratoires et digestifs sévères.
Astronomie & Espace - 01.07.2020

Une équipe internationale d'astronomes, dont des chercheurs de l'UNIGE, a découvert le premier noyau mis à nu d'une planète. TOI 849-b est une planète plutôt singulière: elle a non seulement été trouvée dans «le désert des Neptunes» (une région proche des étoiles où presqu-aucune planète de cette taille et de cette densité n'évolue), mais elle est également dépourvue d'atmosphère, laissant son noyau à nu.
Sciences sociales - Psychologie - 30.06.2020

En traquant les mouvements oculaires, des scientifiques de l'Université de Genève montrent comment les enfants établissent spontanément sans consigne un lien entre une émotion (joie ou colère) exprimée par une voix puis par un visage naturel ou virtuel. Les enfants doivent-ils attendre l'âge de huit ans pour reconnaitre spontanément, sans consigne, une même émotion, joie ou colère, selon qu'elle est exprimée par la voix ou par un visage?
Sciences de la vie - 26.06.2020

Des scientifiques de l'Université de Genève ont mis au point un modèle neuro-informatique, alliant oscillations neuronales et codage prédictif, qui permet d'expliquer comment le cerveau identifie les syllabes dans la parole naturelle. Le rythme des syllabes Les scientifiques genevois-es ont mis au point un modèle neuro-informatique inspiré de ces rythmes physiologiques, dont les performances de séquençage des syllabes en direct (on-line) se sont révélées supérieures à celles des systèmes traditionnels de reconnaissance automatique de la parole.
Santé - Pharmacologie - 25.06.2020

Des scientifiques de l'Université de Genève et des HUG ont identifié les parties de l'enveloppe du SARS-Cov-2 qui sont le plus fréquemment visées par les anticorps. Elles représentent une cible potentielle pour le développement d'un vaccin. Les tests sérologiques permettent de savoir si une personne a développé ou non des anticorps contre le coronavirus responsable du COVID-19.
Sciences de la vie - Pédagogie - 17.06.2020

Un dialogue neuronal efficace entre le circuit de la récompense et celui de la mémoire permet une bonne consolidation des souvenirs dans notre cerveau. Une découverte qui pourrait être appliquée à de nombreuses situations d'apprentissage. Comment fonctionne notre mémoire et comment, au quotidien, en optimiser les mécanismes? Cette question est au centre des préoccupations de nombreuses recherches en neurosciences.
Santé - Sciences sociales - 12.06.2020

Au cours des cinq semaines qu'a duré l'étude - soit du 6 avril au 9 mai - la séroprévalence globale a augmenté d'environ 5 % à 11 %. En prenant en compte le temps nécessaire à la production d'anticorps après les symptômes (10,4 jours en médiane), les chercheurs ont estimé à environ 12 le nombre d'infections réelles dans la communauté pour chaque cas confirmé.
Santé - Sciences de la vie - 10.06.2020

Les populations du globe ne disposent pas toutes d'une immunité identique pour se défendre contre le coronavirus. Une étude de l'Université de Genève fait la comparaison et identifie les variants génétiques potentiellement les plus efficaces. Existe-t-il des différences d'immunité face au coronavirus SARS-CoV-2 entre populations de diverses régions géographiques? Une partie de la réponse est à rechercher dans les génomes de ces groupes de personnes et, plus particulièrement, dans les gènes HLA, responsables du système immunitaire dit adaptatif.
Santé - Pharmacologie - 03.06.2020

Une étude multicentrique menée par une équipe de l'UNIGE, des HUG, du CHUV et de l'Hôpital de St-Gall démontrent qu'un usage plus restreint des antibiotiques est tout aussi efficace, tout en limitant l'apparition de résistances. L'augmentation de la résistance aux antibiotiques et le manque de nouvelles molécules constituent à l'heure actuelle un problème majeur de la santé mondiale.
Santé - Pharmacologie - 28.05.2020

Les Hôpitaux Universitaires de Genève (HUG), la Faculté de Médecine de l'Université de Genève (UNIGE), le Centre de Recherche en Infectiologie de l'Université Université Laval de Québec (Canada) et M
Astronomie & Espace - 28.05.2020

L'existence d'une planète de la taille de la Terre autour de l'étoile la plus proche du système solaire, Proxima Centauri, a été confirmée par une équipe internationale de scientifiques comprenant des chercheurs de l'Université de Genève. Les résultats, publiés dans la revue Astronomy & Astrophysics, révèlent que la planète en question, Proxima b, a une masse de 1,17 masse terrestre et se trouve dans la zone habitable de son étoile, dont elle fait le tour en 11,2 jours.
Santé - Pharmacologie - 18.05.2020
Une méta-analyse menée par une équipe de l-Université de Genève et des HUG montre qu-une infection par le virus de l-hépatite D, dont le dépistage est souvent négligé, multiplie par trois le risque de développer un cancer du foie. Parmi tous les virus de l-hépatite, le D est le plus mal connu. En effet, ce petit virus, qui ne peut infecter que les personnes déjà atteintes par l-hépatite B, n-a jusqu-ici été que peu étudié.
Astronomie & Espace - 16.04.2020

Le télescope spatial CHEOPS a dépassé les espérances des scientifiques en matière de précision. Une nouvelle étape est franchie pour CHEOPS: après plus de trois mois de tests effectués par le personnel de la mission, en partie depuis leur domicile en raison de l'épidémie de coronavirus, le télescope spatial a été déclaré entièrement opérationnel.
Astronomie & Espace - 16.04.2020

Une équipe internationale d'astronomes, dont des chercheurs de l'Université de Genève, a découvert un système compact de six planètes autour de l'étoile HD 158259. Observée par le spectrographe SOPHIE, situé à l'Observatoire de Haute-Provence en France, HD 158259 est une étoile de la constellation du dragon à la limite de la détection à l'oeil nu.
Physique - 15.04.2020

Une équipe scientifique internationale a réussi à détecter une manifestation de la brisure de la symétrie fondamentale de la nature qui a permis à la matière de dominer l'Univers au détriment de l'antimatière. La symétrie de la nature est brisée: l'Univers est constitué de matière tandis que l'antimatière, qui a pourtant été produite à l'origine en parts égales, a presque totalement disparu.











